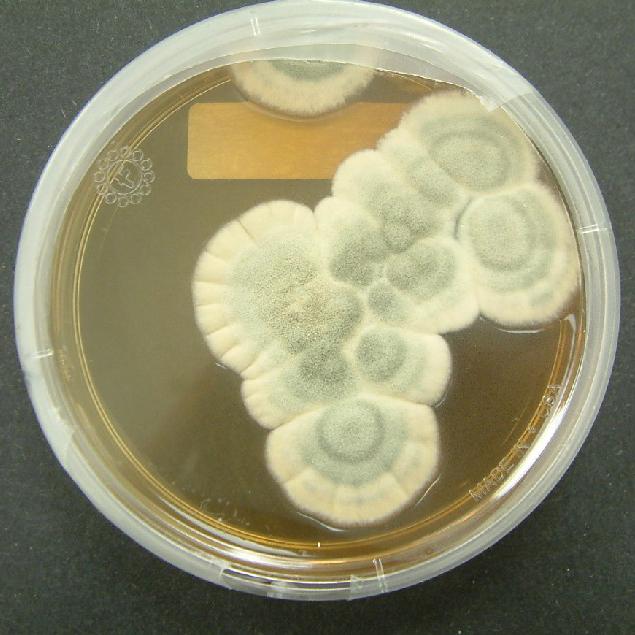

Cuáles son los beneficios de los hongos


Los hongos son unos organismos eucariotas que conforman un reino diferenciado del animal y el vegetal denominado 'Fungi'. No forman parte de los vegetales porque estos están compuestos por celulosa mientras que los hongos cuentan con paredes celulares de quitina. Dentro del reino de los hongos encontramos los mohos, las setas y las levaduras. Todos los hongos comestibles presentan una infinidad de beneficios para nuestra salud, por ello su uso se ha expandido enormemente en medicina. Si quieres saber cómo te benefician los hongos, sigue leyendo este artículo de unComo.
Pasos a seguir:
Los hongos son muy utilizados tanto en la alimentación como en la medicina. De hecho, conforman uno de los mayores aportes de la historia de la medicina, la penicilina. Este importante antibiótico se extrae del género de hongos llamado Penicillium, de los cuales se obtienen los diferentes tipos de penicilinas.

Los hongos contienen un porcentaje muy bajo de calorías y alrededor del 80% de su composición es agua, lo cual los convierte en un alimento excelente para todas aquellas personas que quieran mantener su peso ideal o reducirlo.
Su alto contenido de proteínas y vitaminas hacen de los hongos un alimento muy beneficioso para nuestro organismo. Destacan la vitamina B1 y B2, las cuales favorecen la mejora del tejido muscular, del sistema inmunológico y la creación de glóbulos rojos, y la vitamina D, excelente para mantener en perfecto estado nuestros huesos.
En concreto, el hongo cordyceps aporta una inifinidad de beneficios para nuestra salud. Favorece el aumento del rendimiento y la creación de ATP, ideal para los atletas. Mejora el flujo sanguíneo, los niveles de colesterlo y cuenta con propiedades antidepresivas. Además, numeros estudios demuestran que presenta efectos antitumorales debido a su contenido de cordicepina y, por ello, se está introduciendo en medicamentos contra el cáncer. También es un potente antiinflamatorio, ideal para tratar la artritis reumatoide, entre otras enfermedades.

Otro de los beneficios más importantes es que en la composición de los hongos encontramos ocho de los nueve aminoácidos esenciales para nuestro cuerpo, puesto que por sí solo nuestro organismo no los produce.
Los hongos tienen un alto contenido en niacina, una vitamina del complejo B hidrolosuble, lo cual significa que se disuelve con el agua y no se almacena en nuestro cuerpo, por tanto debemos reponerla mediante alimentos contínuamente. Esta vitamina favorece el correcto funcionamiento del sistema digestivo y es muy beneficiosa para nuestra piel.
Por último, destaca su aporte de glúcidos y carbohidratos, ideales para los músculos, mantener la temperatura corporal, la actividad neuronal y la tensión arterial, entre otros. Como ves, los hongos presentan una multitud de beneficios para nuestra salud, de manera que no dudes en incluirlos en tu dieta. Consulta este artículo para conocer cuáles son las setas tóxicas.
Este artículo es meramente informativo, en unCOMO no tenemos facultad para recetar ningún tratamiento médico ni realizar ningún tipo de diagnóstico. Te invitamos a acudir a un médico en el caso de presentar cualquier tipo de condición o malestar.
Si deseas leer más artículos parecidos a Cuáles son los beneficios de los hongos, te recomendamos que entres en nuestra categoría de Vida saludable.